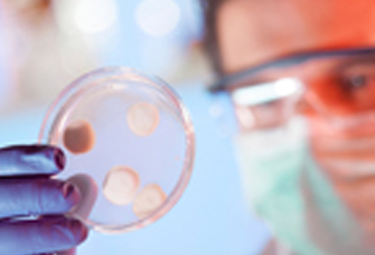

格拉布斯研究院
深圳格拉布斯研究院是深圳市重點(diǎn)支持的國(guó)際化研究機(jī)構(gòu)。研究院借助格拉布斯教授在催化化學(xué)與材料化學(xué)領(lǐng)域的國(guó)際影響力,吸引中外頂尖科學(xué)家和團(tuán)隊(duì)加盟合作,旨在發(fā)展成一個(gè)具有中國(guó)特色及相應(yīng)國(guó)際影響力的基礎(chǔ)科學(xué)研究中心。研究院將圍繞均相催化研究領(lǐng)域,聚焦源頭創(chuàng)新的科研工作,力爭(zhēng)成果產(chǎn)業(yè)化,以推動(dòng)深圳相關(guān)產(chǎn)業(yè)的升級(jí)發(fā)展。
杰曼諾夫數(shù)學(xué)中心
南科大杰曼諾夫數(shù)學(xué)中心是深圳市政府出資、南科大牽頭建設(shè)的深圳市諾獎(jiǎng)科研實(shí)驗(yàn)室,旨在提升和引領(lǐng)深圳市、粵港澳大灣區(qū)及中國(guó)南方在基礎(chǔ)數(shù)學(xué)、應(yīng)用數(shù)學(xué)、計(jì)算數(shù)學(xué)等方面的科學(xué)研究。中心將以純粹數(shù)學(xué)和應(yīng)用數(shù)學(xué)的重要研究領(lǐng)域?yàn)榘l(fā)展方向,致力于推動(dòng)中國(guó)數(shù)學(xué)基礎(chǔ)理論以及數(shù)學(xué)與生命、信息、工程、金融等領(lǐng)域的交叉研究與應(yīng)用發(fā)展,解決重大科學(xué)問(wèn)題,服務(wù)國(guó)家和地方的重大需求。
數(shù)學(xué)中心根據(jù)國(guó)際化的要求,按國(guó)際標(biāo)準(zhǔn)和規(guī)則運(yùn)行,將營(yíng)造一流的學(xué)術(shù)條件和環(huán)境,通過(guò)專(zhuān)題學(xué)術(shù)年和研究室創(chuàng)新團(tuán)隊(duì)的活動(dòng),把中心建設(shè)成為世界級(jí)的國(guó)際化數(shù)學(xué)研究與交流平臺(tái)和一流的人才引進(jìn)和培養(yǎng)平臺(tái),打造一支國(guó)際領(lǐng)先的研究隊(duì)伍, 全面提升數(shù)學(xué)研究和教育水平。


斯發(fā)基斯可信自主系統(tǒng)研究院
斯發(fā)基斯可信自主系統(tǒng)研究院是由圖靈獎(jiǎng)獲得者Joseph Sifakis教授牽頭、整合南方科技大學(xué)計(jì)算機(jī)科學(xué)與工程系優(yōu)勢(shì)科研力量組建的可信智能自主系統(tǒng)研究機(jī)構(gòu)。研究院依托于南科大計(jì)算機(jī)科學(xué)與工程系和深圳市計(jì)算智能重點(diǎn)實(shí)驗(yàn)室、授牌于2019年11月,其研究領(lǐng)域覆蓋計(jì)算智能、可信軟件、自動(dòng)駕駛、智慧城市和智慧醫(yī)療等重點(diǎn)前沿方向。研究院自成立以來(lái),始終以國(guó)家科技發(fā)展需求為導(dǎo)向,以“理技融合”為總體指導(dǎo)思想,開(kāi)展可信智能自主系統(tǒng)的基礎(chǔ)科學(xué)理論研究和工程技術(shù)應(yīng)用研究;同時(shí),研究院將建設(shè)產(chǎn)業(yè)應(yīng)用、國(guó)際合作、人才培養(yǎng)三個(gè)支撐服務(wù)平臺(tái),為持續(xù)的科學(xué)技術(shù)研究提供支撐,努力建成世界一流的可信智能自主系統(tǒng)研究院,提升深圳人工智能科技水平,推動(dòng)人工智能產(chǎn)業(yè)升級(jí),促進(jìn)區(qū)域經(jīng)濟(jì)增長(zhǎng)。
深圳市細(xì)胞微環(huán)境重點(diǎn)實(shí)驗(yàn)室
實(shí)驗(yàn)室的研究以細(xì)胞與細(xì)胞微環(huán)境之間的交互作用為核心,利用模式生物、細(xì)胞技術(shù)、分子技術(shù)、工程模擬等多種研究手段,緊緊圍繞細(xì)胞-微環(huán)境相互作用在人類(lèi)疾病、發(fā)育和生物農(nóng)業(yè)中的重要作用等,進(jìn)行多層面,多方位、多領(lǐng)域的研究。同時(shí)結(jié)合基礎(chǔ)研究開(kāi)發(fā)有應(yīng)用前景的生物材料、生物醫(yī)藥用于相關(guān)疾病的治療;發(fā)掘重要的植物基因資源用于生物育種,并從新的角度研究生物農(nóng)業(yè)抗病蟲(chóng)、抗脅迫的機(jī)制和防治。

深圳市納米壓印技術(shù)重點(diǎn)實(shí)驗(yàn)室
實(shí)驗(yàn)室的研究方向包括:納米壓印設(shè)備及納米壓印工藝和材料開(kāi)發(fā)和納米壓印技術(shù)應(yīng)用研究,力求在關(guān)鍵設(shè)備、工藝和材料、工程應(yīng)用等方面取得多項(xiàng)原創(chuàng)知識(shí)產(chǎn)權(quán)和專(zhuān)利,填補(bǔ)深圳市、廣東省和國(guó)家在高端納米壓印技術(shù)領(lǐng)域的空白,為后期成功實(shí)現(xiàn)產(chǎn)業(yè)化和經(jīng)濟(jì)效益奠定基礎(chǔ)。同時(shí)實(shí)驗(yàn)室也秉承面向社會(huì)、講求實(shí)效、資源共享的原則,為深圳市高等院校、科研機(jī)構(gòu)和高新技術(shù)企業(yè)提供科研、培訓(xùn)、咨詢(xún)和技術(shù)開(kāi)發(fā)服務(wù),對(duì)外開(kāi)放重點(diǎn)實(shí)驗(yàn)室平臺(tái)設(shè)備。
深圳市第三代半導(dǎo)體器件重點(diǎn)實(shí)驗(yàn)室
以氮化鎵(GaN)和碳化硅(SiC)等寬禁帶材料為代表的第三代半導(dǎo)體材料和器件在高壓、高功率、高頻率、高效率等應(yīng)用領(lǐng)域嶄露頭角,展現(xiàn)出巨大的應(yīng)用前景。本實(shí)驗(yàn)室圍繞第三代半導(dǎo)體器件開(kāi)展研究,致力于GaN功率器件和封裝技術(shù)開(kāi)發(fā),解決Si襯底GaN功率器件外延生長(zhǎng)和制備中的關(guān)鍵問(wèn)題,結(jié)合器件可靠性研究,最終實(shí)現(xiàn)了高質(zhì)量的兼容CMOS工藝的Si基GaN功率器件,并同時(shí)開(kāi)發(fā)了靈敏度高的適合生物、化學(xué)物檢測(cè)的傳感器及適合平板顯示器所用的高性能開(kāi)關(guān)器件。實(shí)驗(yàn)室旨在建立起開(kāi)放性的平臺(tái)和“產(chǎn)學(xué)研”一體化的科研模式,積極開(kāi)展國(guó)內(nèi)國(guó)際學(xué)術(shù)科技交流,目前已建成包含電子束曝光機(jī)、光罩曝光機(jī)、RIE、電子束蒸鍍膜系統(tǒng)、LPCVD、ALD、ICP、PECVD等設(shè)備的完整 6英寸CMOS工藝線(xiàn)。實(shí)驗(yàn)室建設(shè)推進(jìn)了我國(guó)在第三代半導(dǎo)體材料應(yīng)用領(lǐng)域的技術(shù)進(jìn)步,培養(yǎng)了第三代半導(dǎo)體相關(guān)研究的自主創(chuàng)新能力,布局具有自主知識(shí)產(chǎn)權(quán)的核心技術(shù)和產(chǎn)品,并通過(guò)產(chǎn)業(yè)化的推進(jìn)加快第三代半導(dǎo)體應(yīng)用的普及。


深圳市熱電材料重點(diǎn)實(shí)驗(yàn)室
實(shí)驗(yàn)室主要圍繞熱電材料研究與熱電器件開(kāi)發(fā)兩個(gè)方面展開(kāi)工作。立足于深圳市良好的科研與產(chǎn)業(yè)環(huán)境、利用依托單位南方科技大學(xué)材料、物理、化學(xué)等學(xué)科的交叉優(yōu)勢(shì),以“競(jìng)爭(zhēng)、協(xié)作、開(kāi)放、流動(dòng)”的運(yùn)行機(jī)制和“進(jìn)取、嚴(yán)謹(jǐn)、務(wù)實(shí)”的科研氛圍為導(dǎo)向,借助先進(jìn)的現(xiàn)代表征手段和方法,圍繞研究熱電材料的熱電傳輸機(jī)理;提高熱電材料和器件的熱電轉(zhuǎn)換效率;推進(jìn)熱電材料和器件的產(chǎn)業(yè)化;并致力于為解決能源危機(jī)和環(huán)境問(wèn)題提出高效解決方案。
深圳市有機(jī)半導(dǎo)體印刷材料與器件重點(diǎn)實(shí)驗(yàn)室
實(shí)驗(yàn)室以發(fā)展新型高性能有機(jī)半導(dǎo)體材料為核心,開(kāi)發(fā)具有自主知識(shí)產(chǎn)權(quán)的應(yīng)用于場(chǎng)效應(yīng)晶體管、太陽(yáng)能電池、光電探測(cè)器等的材料體系。建立包括分子結(jié)構(gòu)、光電性質(zhì)等相關(guān)的表征平臺(tái),對(duì)材料性質(zhì)進(jìn)行全面表征,以便對(duì)材料進(jìn)行優(yōu)化。重點(diǎn)研究有機(jī)半導(dǎo)體材料的溶液法印刷成膜工藝,通過(guò)分子結(jié)構(gòu)、添加劑以及溶劑控制,實(shí)現(xiàn)有機(jī)半導(dǎo)體材料的高通量、大面積、適合柔性襯底的印刷加工。建立一個(gè)完善的有機(jī)半導(dǎo)體印刷電子研究平臺(tái),研究能力處于國(guó)內(nèi)領(lǐng)先、國(guó)際一流的水平。


深圳市土壤與地下水污染防治重點(diǎn)實(shí)驗(yàn)室
實(shí)驗(yàn)室針對(duì)我國(guó)水、土污染防治需求,在開(kāi)展地下水與土壤污染重大基礎(chǔ)研究的基礎(chǔ)上,結(jié)合社會(huì)需求,積極開(kāi)展地下水與土壤污染勘探、快速檢測(cè)、污染模擬、污染評(píng)價(jià)、健康風(fēng)險(xiǎn)評(píng)估、修復(fù)等技術(shù)開(kāi)發(fā)及環(huán)境咨詢(xún)與工程技術(shù)服務(wù)。促進(jìn)和推動(dòng)深圳市水、土污染環(huán)保產(chǎn)業(yè)的科技化發(fā)展,形成深圳市土壤、地下水污染調(diào)查、評(píng)價(jià)、管理、規(guī)劃和決策的實(shí)驗(yàn)室及技術(shù)支撐平臺(tái),成為深圳市土壤、地下水污染修復(fù)及管理的智庫(kù)。
深圳市氫能重點(diǎn)實(shí)驗(yàn)室
實(shí)驗(yàn)室主要研發(fā)任務(wù)是搭建一個(gè)電解水制氫的深圳市重點(diǎn)實(shí)驗(yàn)室共享平臺(tái),平臺(tái)具備PEM電解水制氫系統(tǒng)的設(shè)計(jì)、組裝及測(cè)試能力,實(shí)驗(yàn)室專(zhuān)注于研究酸性電解水制氫的技術(shù),掌握催化劑、雙極板及單電池等關(guān)鍵組分的工藝及工程技術(shù)。具體的研發(fā)任務(wù)為: (1) 用于PEM電解水制氫的非貴金屬析氫電催化材料與析氫電極的研究; (2) PEM電解水制氫的單電池的設(shè)計(jì)及綜合流體仿真; (3) 電堆一致性與系統(tǒng)一體化集成設(shè)計(jì)的研究。目標(biāo)是建立一個(gè)以酸性電解水制氫(PEM electrolysis)為主的氫能技術(shù)重點(diǎn)實(shí)驗(yàn)室,為填補(bǔ)國(guó)內(nèi)在該領(lǐng)域的技術(shù)空白及為實(shí)現(xiàn)氫能技術(shù)在深圳市的產(chǎn)業(yè)化打造基礎(chǔ),而且并能在短期內(nèi)把南方科技大學(xué)和深圳在氫氣制備技術(shù)領(lǐng)域提升到國(guó)際領(lǐng)先水平。


全光譜發(fā)電功能材料重點(diǎn)實(shí)驗(yàn)室
實(shí)驗(yàn)室專(zhuān)注于太陽(yáng)能全光譜發(fā)電技術(shù)研究和開(kāi)發(fā),重點(diǎn)研發(fā)太陽(yáng)光譜分光和聚光材料、新型高效光伏材料及器件和高熱容熱存儲(chǔ)材料。南科大材料系何祝兵教授和化學(xué)系何振宇教授分別擔(dān)任實(shí)驗(yàn)室正副主任,固定研究人員22人,其中具有博士學(xué)位科研人員10人。擁有先進(jìn)的復(fù)合光學(xué)鍍膜系統(tǒng)、PECVD、PVD、ALD等薄膜物理沉積設(shè)備,和完備的化學(xué)合成和檢測(cè)表征平臺(tái)。至今,已經(jīng)在Adv. Mater.、Angew. Chem. Int.等國(guó)際頂尖學(xué)術(shù)期刊發(fā)表論文20余篇,申請(qǐng)專(zhuān)利近30項(xiàng)。光伏電池冠軍效率接近20%,并研發(fā)出一批高質(zhì)量的光學(xué)薄膜材料設(shè)計(jì)與制備工藝技術(shù)。
城市固體廢棄物資源化技術(shù)與管理重點(diǎn)實(shí)驗(yàn)室
實(shí)驗(yàn)室依托南方科技大學(xué)環(huán)境學(xué)院,于2016年4月獲深圳市科技創(chuàng)新委員會(huì)資助建立。
實(shí)驗(yàn)室實(shí)行“開(kāi)放、流動(dòng)、聯(lián)合、競(jìng)爭(zhēng)”的運(yùn)行機(jī)制,實(shí)行在依托單位的領(lǐng)導(dǎo)下和學(xué)術(shù)委員會(huì)的指導(dǎo)下的主任負(fù)責(zé)制。實(shí)驗(yàn)室主任為劉崇炫教授,執(zhí)行主任張作泰副教授,實(shí)驗(yàn)室擬配備26名科研人員,其中學(xué)術(shù)帶頭人3名。實(shí)驗(yàn)室人員主要為來(lái)自城市固廢資源化技術(shù)與管理領(lǐng)域?qū)W術(shù)界和工程界的高端人才,包括固廢綜合利用領(lǐng)域知名企業(yè)家、教授,國(guó)家優(yōu)秀青年基金獲得者、孔雀計(jì)劃獲得者、高級(jí)工程師等。


深圳市計(jì)算智能重點(diǎn)實(shí)驗(yàn)室
深圳市計(jì)算智能重點(diǎn)實(shí)驗(yàn)室圍繞低能耗、輕量級(jí)、高可靠、可自主演化的計(jì)算智能共性技術(shù)集中攻關(guān),面向互聯(lián)網(wǎng)、軟件服務(wù)行業(yè),與相關(guān)企業(yè)密切對(duì)接,將高端研發(fā)與產(chǎn)業(yè)轉(zhuǎn)化密切結(jié)合,打造基礎(chǔ)理論——關(guān)鍵技術(shù)——產(chǎn)業(yè)應(yīng)用的完整上下游,為互聯(lián)網(wǎng)、軟件服務(wù)等行業(yè)以及智能制造、智慧醫(yī)療、智慧物流等新興方向的發(fā)展提供關(guān)鍵的底層技術(shù)。
深圳市高機(jī)能材料增材制造重點(diǎn)實(shí)驗(yàn)室
深圳市高機(jī)能材料增材制造重點(diǎn)實(shí)驗(yàn)室建設(shè)是為了響應(yīng)“中國(guó)制造2025”產(chǎn)業(yè)發(fā)展戰(zhàn)略,滿(mǎn)足深圳市產(chǎn)業(yè)轉(zhuǎn)型和技術(shù)升級(jí)的需要,突破現(xiàn)有技術(shù)瓶頸,開(kāi)發(fā)具有自主知識(shí)產(chǎn)權(quán)的高機(jī)能材料(涵蓋金屬、高分子陶瓷)粉體制備技術(shù)、3D打印關(guān)鍵技術(shù)及打印裝備,實(shí)現(xiàn)在航空、汽車(chē)結(jié)構(gòu)件、模具行業(yè)與通訊產(chǎn)品領(lǐng)域的大規(guī)模應(yīng)用。實(shí)驗(yàn)室實(shí)行開(kāi)放式管理,引進(jìn)包括院士在內(nèi)的高層次人才以及青年才俊,高定位干實(shí)事,旨在3-5年內(nèi)把實(shí)驗(yàn)室建設(shè)成為國(guó)內(nèi)先進(jìn)、國(guó)際知名的高機(jī)能材料3D打印理論和技術(shù)研發(fā)中心。


深圳量子點(diǎn)先進(jìn)顯示與照明重點(diǎn)實(shí)驗(yàn)室
本重點(diǎn)實(shí)驗(yàn)室將圍繞新興的量子點(diǎn)顯示與照明技術(shù)領(lǐng)域,建立高效率長(zhǎng)壽命QLED材料、器件、封裝及工藝研發(fā)平臺(tái),為深圳市量子點(diǎn)顯示與照明技術(shù)應(yīng)用研究的開(kāi)展提供支撐平臺(tái)。致力于解決QLED用于顯示及照明所面臨的核心技術(shù)難題,包括高性能量子點(diǎn)及載流子注入傳輸材料、QLED印刷制備工藝、高效激子注入型QLED器件等核心關(guān)鍵技術(shù),目標(biāo)是開(kāi)發(fā)具有原創(chuàng)性和自主知識(shí)產(chǎn)權(quán)的下一代QLED顯示與照明技術(shù)。通過(guò)重點(diǎn)本實(shí)驗(yàn)室,擬提升深圳市、廣東省乃至華南地區(qū)在EL QLED器件、PL On-Chip QLED器件及其相關(guān)量子點(diǎn)顯示與照明技術(shù)研究水平,引領(lǐng)下一代顯示與照明技術(shù)的變革(Game Changer)。
深圳市航空航天復(fù)雜流動(dòng)重點(diǎn)實(shí)驗(yàn)室
實(shí)驗(yàn)室的研究方向涵蓋湍流、氣動(dòng)噪聲、無(wú)人機(jī)氣動(dòng)優(yōu)化設(shè)計(jì)、民機(jī)防冰技術(shù)等領(lǐng)域。通過(guò)整合南方科技大學(xué)流體力學(xué)學(xué)科優(yōu)勢(shì)科研力量,圍繞產(chǎn)業(yè)關(guān)鍵技術(shù)需求,開(kāi)展前沿交叉領(lǐng)域的應(yīng)用基礎(chǔ)研究,為深圳市相關(guān)產(chǎn)業(yè)的快速可持續(xù)發(fā)展提供人才儲(chǔ)備和技術(shù)支撐。將主動(dòng)對(duì)接國(guó)家重大科技需求,積極服務(wù)深圳本地企業(yè),力爭(zhēng)在10年內(nèi)成為具有國(guó)際影響力的航空航天復(fù)雜流動(dòng)研究機(jī)構(gòu)。


深圳市固態(tài)電池研發(fā)重點(diǎn)實(shí)驗(yàn)室
實(shí)驗(yàn)室以高能量密度高安全的固態(tài)電鋰池為核心,集中研發(fā)綜合性能優(yōu)異的固態(tài)電解質(zhì)材料、系統(tǒng)研究電解質(zhì)與電極材料界面性質(zhì)、優(yōu)化改進(jìn)先進(jìn)固態(tài)電池組裝及測(cè)評(píng)方案。重點(diǎn)開(kāi)發(fā)具有自主知識(shí)產(chǎn)權(quán)的新型固態(tài)電解質(zhì)材料,通過(guò)結(jié)構(gòu)設(shè)計(jì)和調(diào)控提升綜合性能,設(shè)計(jì)新型界面。借助理論計(jì)算、大科學(xué)裝置等手段深入研究機(jī)理并建立構(gòu)效關(guān)系,加快新材料研究到產(chǎn)業(yè)應(yīng)用的進(jìn)程,從而推動(dòng)固態(tài)鋰電池大規(guī)模應(yīng)用,構(gòu)建資源節(jié)約型、環(huán)境友好型社會(huì)。
深圳海洋地球古菌組學(xué)重點(diǎn)實(shí)驗(yàn)室
古菌作為三種生命形式之一,在海洋生物地球化學(xué)循環(huán)中扮演著極為重要的角色。為探索其在全球生態(tài)系統(tǒng)中的作用和機(jī)理,實(shí)驗(yàn)室將圍繞古菌展開(kāi)四個(gè)方向的研究:1)古菌生命演化;2)古菌生態(tài)功能及代謝機(jī)理;3)海洋古菌資源的開(kāi)發(fā)利用;4)古菌近海與河口生態(tài)修復(fù)。重點(diǎn)建設(shè)古菌脂質(zhì)組學(xué)數(shù)據(jù)庫(kù);鑒定海洋古菌代謝產(chǎn)物;研究海洋古菌脂類(lèi)合成途徑;開(kāi)發(fā)近海污染治理的微生物新技術(shù);形成國(guó)際一流的科研和教學(xué)團(tuán)隊(duì),引領(lǐng)全球海洋古菌組學(xué)。


深圳市新型量子功能材料和器件重點(diǎn)實(shí)驗(yàn)室
深圳市新型量子功能材料和器件重點(diǎn)實(shí)驗(yàn)室聚焦磁性拓?fù)浣^緣材料,強(qiáng)關(guān)聯(lián)材料,二維量子材料等新型量子功能材料的各種新奇物理特性及其對(duì)未來(lái)電子器件、信息通訊,量子計(jì)算和能源等領(lǐng)域的重要應(yīng)用,建立針對(duì)量子材料和器件研究的材料生長(zhǎng)-設(shè)計(jì)-表征-器件-物理解釋的完善研究體系,以期對(duì)在量子功能材料應(yīng)用中普遍存在的共性問(wèn)題提出系統(tǒng)性針對(duì)解決方法,逐步建立深圳乃至我國(guó)在該領(lǐng)域基礎(chǔ)科學(xué)研究中的國(guó)際領(lǐng)先地位。同時(shí)面向未來(lái)量子功能材料和器件的產(chǎn)業(yè)應(yīng)用需求,對(duì)未來(lái)基于該材料的器件應(yīng)用開(kāi)展前瞻性探索。
深圳市小分子藥物發(fā)現(xiàn)與合成重點(diǎn)實(shí)驗(yàn)室
實(shí)驗(yàn)室將立足小分子藥物研發(fā)學(xué)科前沿,聚焦藥物新靶點(diǎn)的發(fā)現(xiàn)、生理活性先導(dǎo)化合物高效合成和活性評(píng)估以及手性藥物合成關(guān)鍵技術(shù)的創(chuàng)制。借助計(jì)算機(jī)輔助藥物設(shè)計(jì)和人工智能技術(shù)加速新藥物研發(fā),力爭(zhēng)在實(shí)驗(yàn)室建設(shè)周期內(nèi)發(fā)現(xiàn)和合成多類(lèi)具備新穎結(jié)構(gòu)和高度活性的小分子先導(dǎo)化合物。同時(shí),將結(jié)合廣東省大型藥企對(duì)于重大藥物及原料藥中間體的戰(zhàn)略性需求,發(fā)展具有競(jìng)爭(zhēng)力的手性藥物合成關(guān)鍵技術(shù),為粵港澳大灣區(qū)乃至國(guó)家在新藥開(kāi)發(fā)和藥物研發(fā)關(guān)鍵技術(shù)創(chuàng)制等領(lǐng)域做出創(chuàng)新與貢獻(xiàn)。


深圳市深遠(yuǎn)海油氣勘探技術(shù)重點(diǎn)實(shí)驗(yàn)室
深遠(yuǎn)海油氣資源是我國(guó)深海戰(zhàn)略重點(diǎn)目標(biāo)之一,也是粵港澳大灣區(qū)經(jīng)濟(jì)建設(shè)切實(shí)需求。本實(shí)驗(yàn)室建設(shè)旨在深入開(kāi)展南海深水油氣資源勘探開(kāi)發(fā)的基礎(chǔ)理論及方法技術(shù)研究,搭建深遠(yuǎn)海資源勘探開(kāi)發(fā)科學(xué)研究平臺(tái)。主要研究方向?yàn)槟虾S蜌狻⒖扇急?、新能源及礦藏地質(zhì)理論,智能化深水深地高精度地球物理勘探開(kāi)發(fā)技術(shù)、儀器裝備及其產(chǎn)品化等。形成深遠(yuǎn)??碧礁叨巳瞬抨?duì)伍培養(yǎng)、地球物理勘探技術(shù)產(chǎn)品研發(fā)及深水探測(cè)科研創(chuàng)新中心。積極承接國(guó)家和行業(yè)重大科技需求,拓展國(guó)際交流與合作,融合理論方法研究與行業(yè)應(yīng)用基礎(chǔ)研究,匯聚和培養(yǎng)行業(yè)新型人才,多方位立體化服務(wù)于深圳市、廣東省和我國(guó)的資源勘探和海洋經(jīng)濟(jì)的發(fā)展。實(shí)驗(yàn)室的目標(biāo)是以創(chuàng)新為動(dòng)力,主攻深水勘探開(kāi)發(fā)理論、方法技術(shù)及裝備等關(guān)鍵目標(biāo),力爭(zhēng)在10年內(nèi)將實(shí)驗(yàn)室建設(shè)成為有國(guó)際影響力的深遠(yuǎn)海油氣勘探研究和創(chuàng)新人才培養(yǎng)基地。
深圳市仿生機(jī)器人與智能系統(tǒng)重點(diǎn)實(shí)驗(yàn)室
深圳市仿生機(jī)器人與智能系統(tǒng)重點(diǎn)實(shí)驗(yàn)室為深圳市科創(chuàng)委批復(fù)建設(shè)的科研平臺(tái),其依托南方科技大學(xué)機(jī)器人研究院,聚焦機(jī)器人領(lǐng)域的前瞻研究和創(chuàng)新應(yīng)用,以仿生研究為主線(xiàn), 面向軍民融合和粵港澳大灣區(qū)產(chǎn)業(yè),研究“仿生驅(qū)動(dòng)”、“仿生操作”、“仿生移動(dòng)”和“人-機(jī)-環(huán)智能融合”等技術(shù), 搭建仿生機(jī)器人與智能系統(tǒng)集成技術(shù)平臺(tái), 解決系列前沿技術(shù)問(wèn)題, 取得突破性的創(chuàng)新成果, 為深圳市機(jī)器人產(chǎn)業(yè)提供了技術(shù)支撐與人才儲(chǔ)備。


深圳市基因調(diào)控與系統(tǒng)生物學(xué)重點(diǎn)實(shí)驗(yàn)室
“深圳市基因調(diào)控與系統(tǒng)生物學(xué)重點(diǎn)實(shí)驗(yàn)室”依托南方科技大學(xué)生命科學(xué)學(xué)院建設(shè),由深圳市科創(chuàng)委資助,于2021年4月掛牌成立。重點(diǎn)實(shí)驗(yàn)室有14個(gè)獨(dú)立課題組,包括科研人員、博士后、研究生、訪問(wèn)學(xué)者等80多人的科研隊(duì)伍,生命科學(xué)學(xué)院陳煒教授為首屆實(shí)驗(yàn)室主任。
實(shí)驗(yàn)室致力于開(kāi)發(fā)、利用并整合最新系統(tǒng)生物學(xué)、基因組學(xué)、單細(xì)胞組學(xué)等工具,對(duì)基因調(diào)控機(jī)制進(jìn)行多層面和多維度解析,聚焦干細(xì)胞發(fā)育和再生醫(yī)學(xué)、惡性腫瘤發(fā)生發(fā)展、神經(jīng)系統(tǒng)疾病、感染性疾病、新藥研發(fā)等生命健康重大科學(xué)問(wèn)題,探尋針對(duì)以上復(fù)雜疾病的新型精準(zhǔn)診療方案。
深圳市智能醫(yī)學(xué)工程重點(diǎn)實(shí)驗(yàn)室
“深圳市智能醫(yī)學(xué)工程重點(diǎn)實(shí)驗(yàn)室”是深圳市科創(chuàng)委和南方科技大學(xué)共同資助,按照醫(yī)理工融合的建設(shè)思路,建立的一個(gè)具有跨學(xué)科、多元化教學(xué)科研平臺(tái),并把臨床需求作為出發(fā)點(diǎn)和落腳點(diǎn),打通醫(yī)學(xué)從實(shí)驗(yàn)室到臨床應(yīng)用的通路橋梁的市級(jí)實(shí)驗(yàn)室。智能生物工程重點(diǎn)實(shí)驗(yàn)室吸引培養(yǎng)相關(guān)專(zhuān)業(yè)的技術(shù)人才,打造對(duì)基礎(chǔ)醫(yī)療器械制造核心技術(shù)進(jìn)行攻關(guān)的研發(fā)團(tuán)隊(duì),通過(guò)項(xiàng)目研究的技術(shù)產(chǎn)出可對(duì)外進(jìn)行提供技術(shù)服務(wù)和技術(shù)支持,研發(fā)出的相關(guān)醫(yī)療器械設(shè)備將提供給相關(guān)研究領(lǐng)域或有需要的科研單位及個(gè)人使用。以這種方式促進(jìn)各學(xué)科之間的交流,同時(shí)加強(qiáng)與醫(yī)療器械廠商的合作,力求使成果盡快的用于我國(guó)的醫(yī)療事業(yè)服務(wù)中,進(jìn)一步提高我國(guó)的醫(yī)療核心技術(shù)。


深圳市城市環(huán)境健康風(fēng)險(xiǎn)精準(zhǔn)測(cè)量與預(yù)警技術(shù)重點(diǎn)實(shí)驗(yàn)室
深圳市城市環(huán)境健康風(fēng)險(xiǎn)精準(zhǔn)測(cè)量與預(yù)警技術(shù)重點(diǎn)實(shí)驗(yàn)室建于2023年3月,實(shí)行在深圳市政府及深圳市科創(chuàng)委監(jiān)督指導(dǎo)、依托單位(南方科技大學(xué))管理、學(xué)術(shù)委員會(huì)指導(dǎo)下的主任負(fù)責(zé)制。實(shí)驗(yàn)室從健康風(fēng)險(xiǎn)因子篩查和監(jiān)測(cè)、健康風(fēng)險(xiǎn)來(lái)源、污染物演化及暴露途徑、健康風(fēng)險(xiǎn)多維度精準(zhǔn)管控及預(yù)警預(yù)測(cè)等多角度出發(fā),通過(guò)多學(xué)科交叉和聯(lián)合攻關(guān),進(jìn)行基礎(chǔ)科學(xué)及其應(yīng)用技術(shù)研究,既可為深圳市城市環(huán)境健康關(guān)鍵問(wèn)題提供解決方案,又可為深圳市生態(tài)文明建設(shè)提供人才保障;同時(shí),也可為深圳市建設(shè)中國(guó)特色社會(huì)主義先行示范區(qū)提供科技支撐。
實(shí)驗(yàn)室將依托國(guó)際頂尖人才,致力于城市環(huán)境健康風(fēng)險(xiǎn)因子的檢測(cè)與篩查技術(shù)、城市環(huán)境健康風(fēng)險(xiǎn)來(lái)源、污染物演化歸趨機(jī)理及暴露途徑、城市環(huán)境健康風(fēng)險(xiǎn)多維度精準(zhǔn)管控及預(yù)警預(yù)測(cè)技術(shù)等的研發(fā),建設(shè)國(guó)際領(lǐng)先的城市環(huán)境健康產(chǎn)業(yè)孵化基地。本實(shí)驗(yàn)室的建設(shè)不僅可以彌補(bǔ)深圳市相關(guān)領(lǐng)域基礎(chǔ)研究滯后的問(wèn)題,填補(bǔ)相關(guān)領(lǐng)域巨大的經(jīng)濟(jì)、技術(shù)和經(jīng)驗(yàn)缺口,同時(shí)還可以形成相應(yīng)的技術(shù)標(biāo)準(zhǔn)和規(guī)范,打造成熟的標(biāo)準(zhǔn)體系,推動(dòng)深圳市城市環(huán)境健康領(lǐng)域相關(guān)科技企業(yè)的技術(shù)進(jìn)步與行業(yè)的健康發(fā)展。
深圳天然氣水合物重點(diǎn)實(shí)驗(yàn)室(籌建啟動(dòng))
深圳市天然氣水合物重點(diǎn)實(shí)驗(yàn)室依托南方科技大學(xué)前沿與交叉科學(xué)研究院而立,將天然氣水合物科技、高壓科學(xué)與技術(shù)領(lǐng)域的一批國(guó)家級(jí)人才的前沿科學(xué)研究集中起來(lái),聚焦海洋資源開(kāi)發(fā)及生態(tài)可持續(xù)發(fā)展戰(zhàn)略,結(jié)合大灣區(qū)大科學(xué)裝置、科研及產(chǎn)業(yè)優(yōu)勢(shì),研究與天然氣水合物開(kāi)采密切相關(guān)的科學(xué)問(wèn)題,建立成熟的理論模型,為天然氣水合物的安全開(kāi)采提供基礎(chǔ)參數(shù)。立足于天然氣水合物科學(xué)與技術(shù)的發(fā)展與應(yīng)用創(chuàng)新,推動(dòng)新型天然氣水合物綜合表征技術(shù)和先進(jìn)水合物制備和應(yīng)用領(lǐng)域的深度融合。通過(guò)對(duì)天然氣水合物的水文地質(zhì)條件下研究,包括多維測(cè)試系統(tǒng)的研發(fā)和運(yùn)行,精確理論模型的建立,聯(lián)合深圳市及全國(guó)相關(guān)院所開(kāi)展水合物試開(kāi)采模擬,為我國(guó)天然氣水合物商業(yè)化開(kāi)采提供支持。


深圳材料界面科學(xué)與工程應(yīng)用重點(diǎn)實(shí)驗(yàn)室(籌建啟動(dòng))
深圳市材料界面科學(xué)和工程應(yīng)用重點(diǎn)實(shí)驗(yàn)室旨在以材料界面科學(xué)為基石,結(jié)合先進(jìn)材料、表面功能化、界面?zhèn)髻|(zhì)、浸潤(rùn)控制和環(huán)境工程等技術(shù)來(lái)設(shè)計(jì)和開(kāi)發(fā)新型界面功能材料,建立復(fù)雜體系中的表界面行為控制手段,為解決深圳市新能源和傳統(tǒng)能源快速發(fā)展面臨的環(huán)境和資源壓力提供保障。實(shí)驗(yàn)室研究領(lǐng)域包含廢舊動(dòng)力電池復(fù)雜相分離和資源化再利用、界面行為控制修復(fù)含油污泥和土壤、高性能鋰離子電池電極材料制備、高穩(wěn)定超疏水空泡涂層技術(shù)和響應(yīng)性磁性界面材料等五大研究方向。實(shí)驗(yàn)室將與其他院校開(kāi)展廣泛深入的合作,深化合作交流機(jī)制,逐步將本實(shí)驗(yàn)室建設(shè)成為國(guó)內(nèi)一流、國(guó)際先進(jìn)的創(chuàng)新型界面科學(xué)與工程應(yīng)用實(shí)驗(yàn)室,為驅(qū)動(dòng)深圳市產(chǎn)業(yè)可持續(xù)發(fā)展做出重要的貢獻(xiàn)。實(shí)驗(yàn)室由深圳市科創(chuàng)委支持,南科大徐政和院士擔(dān)任實(shí)驗(yàn)室主任。
深圳能源化學(xué)重點(diǎn)實(shí)驗(yàn)室(籌建啟動(dòng))
深圳能源化學(xué)重點(diǎn)實(shí)驗(yàn)室依托南方科技大學(xué)理學(xué)院建立,以自行研制和原創(chuàng)的科學(xué)儀器為基礎(chǔ),開(kāi)展能源化學(xué)轉(zhuǎn)化基礎(chǔ)與應(yīng)用研究。本實(shí)驗(yàn)室開(kāi)展的研究方向以清潔能源發(fā)展問(wèn)題為核心,通過(guò)針對(duì)特定科學(xué)問(wèn)題的儀器研發(fā)、關(guān)鍵科學(xué)問(wèn)題的基礎(chǔ)研究、以研究成果再推動(dòng)儀器研發(fā)的模式,不斷提高相關(guān)基礎(chǔ)研究水平,針對(duì)能源學(xué)轉(zhuǎn)化基礎(chǔ)研究中的熱門(mén)問(wèn)題(例如光催化制氫,原子分子與表面相互作用機(jī)制,原子分子之間相互作用傳能,團(tuán)簇與載體相互作用機(jī)制等)進(jìn)行系統(tǒng)和深入地研究,為工業(yè)應(yīng)用的推廣提供基礎(chǔ),有力推動(dòng)我市能源化學(xué)轉(zhuǎn)化基礎(chǔ)與應(yīng)用研究的發(fā)展。實(shí)驗(yàn)室由深圳市科創(chuàng)委和南方科技大學(xué)共同支持。


深圳市機(jī)器人感知與智能重點(diǎn)實(shí)驗(yàn)室(籌建啟動(dòng))
深圳市機(jī)器人感知與智能重點(diǎn)實(shí)驗(yàn)室(籌)主要圍繞機(jī)器人學(xué)、機(jī)器人感知與智能相關(guān)領(lǐng)域開(kāi)展科技創(chuàng)新與人才培養(yǎng)。實(shí)驗(yàn)室聚焦最前沿機(jī)器人感知與智能的基礎(chǔ)理論和核心技術(shù),以解決機(jī)器人在社會(huì)生產(chǎn)生活中的實(shí)際應(yīng)用痛點(diǎn)問(wèn)題為目標(biāo),開(kāi)展相關(guān)研究。實(shí)驗(yàn)室研究稠密人群動(dòng)態(tài)環(huán)境中的智能人機(jī)交互操作問(wèn)題及其在醫(yī)療和服務(wù)行業(yè)的解決方案,相關(guān)成果將賦能機(jī)器人在動(dòng)態(tài)復(fù)雜結(jié)構(gòu)及稠密人群的場(chǎng)景下高效運(yùn)行,為國(guó)家科技創(chuàng)新發(fā)展目標(biāo)的實(shí)現(xiàn)做出原創(chuàng)性貢獻(xiàn)。同時(shí),本實(shí)驗(yàn)室致力于咽拭子核酸采樣機(jī)器人、靜脈取血與注射機(jī)器人、氣管插管機(jī)器人、超聲掃查機(jī)器人以及醫(yī)療影像分析等領(lǐng)域的研究,著力完成世界首個(gè)傳染病房醫(yī)護(hù)人員全替代智能交互與操作機(jī)器人系統(tǒng)的產(chǎn)品樣機(jī)開(kāi)發(fā)及應(yīng)用示范。
深圳市心血管健康與精準(zhǔn)醫(yī)學(xué)重點(diǎn)實(shí)驗(yàn)室(籌建啟動(dòng))
實(shí)驗(yàn)室通過(guò)建立前瞻性、大樣本的心血管健康相關(guān)人群隊(duì)列,整合臨床數(shù)據(jù)與多模態(tài)生物信息特征,結(jié)合真實(shí)世界人群數(shù)據(jù),探索與心血管健康疾病進(jìn)展相關(guān)的關(guān)鍵生物標(biāo)記物,建立臨床特征與生物標(biāo)記物相結(jié)合的臨床表型和內(nèi) 表型評(píng)估體系, 實(shí)現(xiàn)心血管健康管理的個(gè)體化精準(zhǔn)預(yù)防、診斷及治療策略。實(shí)驗(yàn)室主要研究方向?yàn)椋海?)高質(zhì)量心血管疾病隊(duì)列數(shù)據(jù)和生物資源庫(kù)的建立和數(shù)據(jù)挖掘;(2)個(gè)體化心血管疾病風(fēng)險(xiǎn)綜合預(yù)測(cè)及其應(yīng)用;(3)基于醫(yī)院和社康中心的真實(shí)世界臨床大數(shù)據(jù)分析與挖掘,開(kāi)展心血管疾病防控和健康管理應(yīng)用。


深圳市跨尺度制造力學(xué)重點(diǎn)實(shí)驗(yàn)
深圳市跨尺度制造力學(xué)重點(diǎn)實(shí)驗(yàn)室依托南方科技大學(xué)的創(chuàng)新智造研究院而立,旨在建成高效率的、在智能制造領(lǐng)域具有深遠(yuǎn)影響的綜合研究平臺(tái),為領(lǐng)域發(fā)展提供源源不斷的支持,包括新知識(shí)庫(kù)、創(chuàng)新型人才和突破性技術(shù)等,為深圳市和國(guó)家的宏觀發(fā)展服務(wù)。本重點(diǎn)實(shí)驗(yàn)室堅(jiān)持 “以理學(xué)為創(chuàng)新源泉,以工學(xué)為創(chuàng)新骨干,以國(guó)家重大需求為創(chuàng)新目標(biāo)”的理念,開(kāi)展智能制造領(lǐng)域的開(kāi)拓性研究,包括跨尺度力學(xué)理論、新功能材料、生醫(yī)元器件、光電通訊元器件、超精密機(jī)床、交通運(yùn)輸核心元器件、工業(yè)軟件技術(shù)和人工智能系統(tǒng)的制造等。本重點(diǎn)實(shí)驗(yàn)室已建立了由頂尖科學(xué)家和專(zhuān)家組成的學(xué)術(shù)顧問(wèn)委員會(huì)來(lái)指導(dǎo)其長(zhǎng)遠(yuǎn)發(fā)展,并已初步形成了居于智能制造領(lǐng)域國(guó)際前沿的科研力量。
深圳電磁無(wú)創(chuàng)醫(yī)學(xué)檢測(cè)工程實(shí)驗(yàn)室
實(shí)驗(yàn)室將微波腫瘤檢測(cè)平臺(tái)、毫米波無(wú)創(chuàng)生命體征檢測(cè)平臺(tái)、新型醫(yī)學(xué)成像設(shè)備平臺(tái)和硬件集成成像設(shè)備平臺(tái)的建設(shè),最終建成一個(gè)集技術(shù)研發(fā)及專(zhuān)業(yè)培訓(xùn)一體化的醫(yī)療監(jiān)護(hù)和無(wú)損檢測(cè)應(yīng)用示范基地。同時(shí)實(shí)驗(yàn)室將建成一個(gè)醫(yī)療監(jiān)護(hù)資源中心,連接國(guó)際上同行業(yè)的最新技術(shù),為國(guó)內(nèi)相關(guān)提供行業(yè)全面的信息和技術(shù)資源支持,推動(dòng)行業(yè)標(biāo)準(zhǔn)建立。另外通過(guò)對(duì)核心專(zhuān)利技術(shù)的產(chǎn)業(yè)化推動(dòng)相關(guān)企業(yè)的孵化并進(jìn)行產(chǎn)業(yè)化,進(jìn)一步建立國(guó)內(nèi)領(lǐng)先的醫(yī)療監(jiān)護(hù)和無(wú)損檢測(cè)技術(shù)及產(chǎn)業(yè)化開(kāi)發(fā)與產(chǎn)學(xué)研合作平臺(tái), 推動(dòng)相關(guān)應(yīng)用基礎(chǔ)研究到應(yīng)用技術(shù)的進(jìn)程,并以期促進(jìn)相關(guān)產(chǎn)業(yè)的快速發(fā)展。


深圳航空發(fā)動(dòng)機(jī)3D打印粉材工程實(shí)驗(yàn)室
“深圳航空發(fā)動(dòng)機(jī)3D打印粉材工程實(shí)驗(yàn)室”是深圳市發(fā)改委和南方科技大學(xué)共同資助的,以3D打印為契機(jī)、以航空航天這一深圳市戰(zhàn)略新興產(chǎn)業(yè)為背景、以南科大為依托單位的一個(gè)市級(jí)工程實(shí)驗(yàn)室。實(shí)驗(yàn)室主要研究多種類(lèi)、高品質(zhì)3D打印用粉的核心制備技術(shù),為3D打印航空發(fā)動(dòng)機(jī)零部件提供包括原材料、3D打印工藝、零部件后處理等全環(huán)節(jié)的技術(shù)儲(chǔ)備、智力支持以及人才培養(yǎng)。實(shí)驗(yàn)室的目標(biāo)還包括提升深圳市在航空航天、3D打印等方面的自主創(chuàng)新能力,開(kāi)展產(chǎn)業(yè)技術(shù)攻關(guān),參與重要標(biāo)準(zhǔn)的研究、制定和推廣。
深圳海底地震儀設(shè)備與技術(shù)工程實(shí)驗(yàn)室
實(shí)驗(yàn)室以國(guó)際最先進(jìn)的海底地震觀測(cè)技術(shù)為目標(biāo),將引進(jìn)法國(guó)著名的地學(xué)研究所IPGP的OBS制造技術(shù),迅速實(shí)現(xiàn)規(guī)?;拈_(kāi)發(fā)高性能寬頻帶OBS的能力,解決現(xiàn)階段我國(guó)海底地震觀測(cè)領(lǐng)域所面臨的儀器設(shè)備短缺的問(wèn)題。 在擁有一定規(guī)模的OBS設(shè)備后,實(shí)驗(yàn)室將瞄準(zhǔn)與全球變化有關(guān)的重大科學(xué)問(wèn)題,在重點(diǎn)海區(qū)開(kāi)展一系列的大規(guī)模、臺(tái)陣式的OBS海底觀測(cè)試驗(yàn)。這些海區(qū)和可能的科學(xué)問(wèn)題包括:在南海驗(yàn)證海南地幔熱柱假說(shuō)以及進(jìn)行馬尼拉俯沖帶的地震和海嘯災(zāi)害危險(xiǎn)性分析;在西南印度洋中脊探討超慢速擴(kuò)張洋脊的演化及海底資源潛力分析;在西太平洋探測(cè)海底深淵結(jié)構(gòu);在印度洋中揭示東90度海嶺結(jié)構(gòu)和演化等。實(shí)驗(yàn)室的中期目標(biāo)是在消化和吸收法國(guó)IPGP BBOBS技術(shù)并形成規(guī)模化的開(kāi)發(fā)能力基礎(chǔ)上,依靠技術(shù)創(chuàng)新,進(jìn)一步提高OBS的性能;并在擁有大規(guī)模的OBS設(shè)備后,建立起中國(guó)海底地震觀測(cè)的儀器設(shè)備共享中心,探討有中國(guó)特色的大型科研儀器設(shè)備共享平臺(tái)的機(jī)制。 實(shí)驗(yàn)室的長(zhǎng)期目標(biāo)是直面國(guó)家和深圳市對(duì)海洋權(quán)益保護(hù)、環(huán)境生態(tài)安全及未來(lái)產(chǎn)業(yè)發(fā)展的重大需求,瞄準(zhǔn)海洋領(lǐng)域的重大科學(xué)問(wèn)題,以技術(shù)創(chuàng)新為動(dòng)力、主攻海底動(dòng)力學(xué)過(guò)程,災(zāi)害和資源等社會(huì)效應(yīng)等科學(xué)目標(biāo),將其建設(shè)成為具有國(guó)際影響力的海洋地震科學(xué)研究和創(chuàng)新人才聚集的基地。


深圳車(chē)用燃料電池電堆工程實(shí)驗(yàn)室
本工程實(shí)驗(yàn)室以車(chē)用燃料電池關(guān)鍵材料制備、關(guān)鍵部件設(shè)計(jì)和制作、燃料電池電堆技術(shù)、燃料電池系統(tǒng)集四大模塊為研發(fā)方向,通過(guò)開(kāi)發(fā)車(chē)用燃料電池產(chǎn)品,構(gòu)建“產(chǎn)學(xué)研”機(jī)制,承擔(dān)重大橫向燃料電池技術(shù)開(kāi)發(fā)項(xiàng)目,培養(yǎng)和聚集一批高層次科技人才,從而在近期內(nèi)建立30KW燃料電池電堆開(kāi)發(fā)平臺(tái),目前該工程實(shí)驗(yàn)室掌握低成本、高性能、長(zhǎng)壽命燃料電池電堆技術(shù)及關(guān)鍵材料膜電極的量產(chǎn)工藝技術(shù),預(yù)計(jì)在中遠(yuǎn)期成為國(guó)家級(jí)工程實(shí)驗(yàn)室、技術(shù)成果轉(zhuǎn)化產(chǎn)品銷(xiāo)售超過(guò)100億元。
深圳環(huán)境物聯(lián)網(wǎng)技術(shù)與應(yīng)用工程實(shí)驗(yàn)室
本實(shí)驗(yàn)室聚焦當(dāng)前環(huán)境物聯(lián)網(wǎng)技術(shù)與產(chǎn)業(yè)發(fā)展的瓶頸問(wèn)題,針對(duì)典型應(yīng)用場(chǎng)景,探索環(huán)境物聯(lián)網(wǎng)關(guān)鍵技術(shù)的創(chuàng)新和示范性應(yīng)用,著力打造環(huán)境物聯(lián)網(wǎng)技術(shù)研發(fā)的軟硬件平臺(tái)。在環(huán)境傳感器集成、環(huán)境監(jiān)測(cè)網(wǎng)絡(luò)優(yōu)化技術(shù)、環(huán)境大數(shù)據(jù)分析、復(fù)雜環(huán)境系統(tǒng)模擬、環(huán)境模型數(shù)據(jù)同化與不確定性分析、環(huán)境信息可視化、環(huán)境管理決策優(yōu)化等方面實(shí)現(xiàn)關(guān)鍵技術(shù)創(chuàng)新。獲得環(huán)境物聯(lián)網(wǎng)理論、方法與技術(shù)的豐富儲(chǔ)備,建立一支成熟穩(wěn)定、結(jié)構(gòu)合理、技術(shù)一流的環(huán)境物聯(lián)網(wǎng)技術(shù)研發(fā)團(tuán)隊(duì),建成一個(gè)具有全國(guó)影響力和全球競(jìng)爭(zhēng)力的創(chuàng)新研發(fā)平臺(tái)。推動(dòng)環(huán)境物聯(lián)網(wǎng)產(chǎn)業(yè)在深圳市發(fā)展,服務(wù)深圳市的國(guó)家可持續(xù)發(fā)展議程創(chuàng)新示范區(qū)建設(shè)。本工程實(shí)驗(yàn)室由環(huán)境科學(xué)與工程學(xué)院鄭一教授(國(guó)家“優(yōu)青”)牽頭建設(shè),核心成員包括多位國(guó)家專(zhuān)家。


深圳物聯(lián)網(wǎng)智能信息處理工程實(shí)驗(yàn)室
實(shí)驗(yàn)室依托南方科技大學(xué),以國(guó)家智能制造2025相關(guān)規(guī)劃、深圳市重點(diǎn)發(fā)展戰(zhàn)略相關(guān)規(guī)劃以及粵港澳大灣區(qū)發(fā)展戰(zhàn)略為指導(dǎo)方向,對(duì)接國(guó)家重大項(xiàng)目、省市重大科技產(chǎn)業(yè)專(zhuān)項(xiàng),形成一批具有較強(qiáng)影響力和競(jìng)爭(zhēng)力的核心技術(shù),培養(yǎng)并吸引一流的技術(shù)人才與產(chǎn)業(yè)人才。重點(diǎn)圍繞未來(lái)物聯(lián)網(wǎng)鏈路優(yōu)化、數(shù)據(jù)管理、云邊緣計(jì)算等智能信息處理領(lǐng)域進(jìn)行技術(shù)突破,形成核心技術(shù)平臺(tái),并在工業(yè)領(lǐng)域搭建演示示范場(chǎng)景,構(gòu)建工業(yè)物聯(lián)網(wǎng)等行業(yè)示范應(yīng)用平臺(tái)。
深圳前沿材料高壓制備工程研究中心
“深圳前沿材料高壓制備工程研究中心” 聚焦當(dāng)前高壓科學(xué)與極端條件下前沿新材料(包括能源材料)制備、研究和發(fā)展中遇到的瓶頸問(wèn)題,圍繞高溫高壓技術(shù)與新材料的高壓制備領(lǐng)域,以高壓與高溫極端條件下 (通常大于1萬(wàn)個(gè)大氣壓) 的新材料制備為目的,獲得常壓下無(wú)法制備的新材料。通過(guò)對(duì)壓力、溫度等條件的精確控制,創(chuàng)造有利于新材料形成的熱力學(xué)條件,從而合成高溫超導(dǎo)體、半導(dǎo)體、光學(xué)材料、超硬材料及催化劑等新型功能材料。開(kāi)展大腔體壓機(jī)的溫度、壓力與腔體體積的優(yōu)化工作,進(jìn)行新材料的制備、表征及工業(yè)應(yīng)用評(píng)估工作,重點(diǎn)研究攻克先進(jìn)的大腔體壓機(jī)技術(shù)、及超高壓二級(jí)增壓技術(shù);針對(duì)不同的材料體系,探索與發(fā)展有效的合成路線(xiàn)與方法,為深圳市的新材料制造提供的高壓技術(shù)支持,推動(dòng)極端壓力下的物質(zhì)的基礎(chǔ)科學(xué)研究。


深圳新型電子信息材料與器件工程研究中心
新型電子信息材料與器件工程研究中心是深圳市發(fā)改委和南方科技大學(xué)共同資助的,以高儲(chǔ)能密度介質(zhì)薄膜材料以及電容器、高靈敏度柔性傳感器與可穿戴智能緊身衣等為主要方向的市級(jí)工程研究中心。該中心在應(yīng)用基礎(chǔ)研究、核心技術(shù)攻關(guān)以及成果轉(zhuǎn)移應(yīng)用等方面開(kāi)展系統(tǒng)深入的研究,目標(biāo)是建設(shè)具有國(guó)際水準(zhǔn)的電子信息材料與器件研究平臺(tái),實(shí)現(xiàn)新型電子材料研發(fā)、器件研制的協(xié)同優(yōu)化,通過(guò)材料-器件-機(jī)理-應(yīng)用的長(zhǎng)鏈條貫通式研發(fā),取得一系列有國(guó)際影響的高水平研究成果,為深圳市在電子信息材料與器件領(lǐng)域聚集和培養(yǎng)一批高層次專(zhuān)業(yè)技術(shù)人才。
深圳柔性太陽(yáng)能電池研發(fā)工程研究中心
深圳柔性太陽(yáng)能電池研發(fā)工程研究中心是深圳市發(fā)改委和南方科技大學(xué)共同資助的、以第三代柔性太陽(yáng)能電池材料、器件、測(cè)試技術(shù)以及相關(guān)產(chǎn)業(yè)發(fā)展為主要研發(fā)方向的市級(jí)工程研究中心。該中心在應(yīng)用基礎(chǔ)研究、核心技術(shù)攻關(guān)以及成果轉(zhuǎn)化和產(chǎn)業(yè)化等方面開(kāi)展系統(tǒng)深入的研究,目標(biāo)是建設(shè)成為具有國(guó)際先進(jìn)水平的新型柔性太陽(yáng)能電池研發(fā)平臺(tái),并通過(guò)新型柔性太陽(yáng)能電池材料研究、器件研制和設(shè)備開(kāi)發(fā)的全鏈條研發(fā)和協(xié)同優(yōu)化,取得一系列具有國(guó)際影響的高水平研究成果,為深圳市太陽(yáng)能和新能源產(chǎn)業(yè)的發(fā)展提供重要、可靠的技術(shù)支撐、智力服務(wù)和人才培養(yǎng)。


深圳無(wú)人飛行器設(shè)計(jì)與導(dǎo)航控制技術(shù)工程研究中心
深圳無(wú)人飛行器設(shè)計(jì)與導(dǎo)航控制技術(shù)工程研究中心是深圳市發(fā)展和改革委員會(huì)批復(fù),依托南方科技大學(xué)建設(shè)的市級(jí)工程研究中心,研究中心聚焦先進(jìn)無(wú)人飛行器系統(tǒng)設(shè)計(jì)技術(shù)、無(wú)人飛行器自主導(dǎo)航與控制技術(shù)、智能傳感與測(cè)量技術(shù)等研究方向,開(kāi)展新概念無(wú)人飛行器、自主導(dǎo)航與控制技術(shù)及新型傳感器的應(yīng)用基礎(chǔ)研究、關(guān)鍵技術(shù)攻關(guān)以及成果轉(zhuǎn)化,構(gòu)建創(chuàng)新型、開(kāi)放式的研究平臺(tái),形成高水平研究成果,培養(yǎng)高層次專(zhuān)業(yè)技術(shù)人才,服務(wù)于國(guó)家和深圳市無(wú)人飛行器產(chǎn)業(yè)的發(fā)展。
深圳低質(zhì)煤綜合利用工程研究中心
深圳低質(zhì)煤綜合利用工程研究中心,是由深圳市政府扶持并依托于南方科技大學(xué)的科研實(shí)驗(yàn)平臺(tái)而建設(shè)的。工程研究中心致力于為煤炭等礦產(chǎn)資源清潔高效綜合利用和土壤健康化提供可行的解決方案。該中心圍繞低質(zhì)煤炭等礦產(chǎn)資源清潔化和高值化利用等領(lǐng)域開(kāi)展工作,包括微納尺度下礦物顆粒高效解離與分離過(guò)程的核心規(guī)律探索、煤中可燃物與礦物質(zhì)在遠(yuǎn)低于傳統(tǒng)顆粒尺度下的加工利用新方法、國(guó)內(nèi)外低質(zhì)煤清潔化和高值化利用技術(shù)的資源整合與集成開(kāi)發(fā)。主要研發(fā)目標(biāo)是形成礦物顆粒高效解離與分離工藝及裝備、高熱值水煤漿制備工藝及裝備、礦物分離及應(yīng)用核心添加劑、高附加值碳素材料和新型天然礦物土壤改良劑。


南方科技大學(xué)金融科技與金融創(chuàng)新研究中心
南方科技大學(xué)金融科技與金融創(chuàng)新研究中心,是以金融系王蘇生教授為負(fù)責(zé)人獲批的,首批七個(gè)深圳市人文社科重點(diǎn)研究基地之一。三個(gè)研究方向:金融科技研究、中國(guó)金融穩(wěn)定研究、金融保險(xiǎn)精算研究。該研究中心專(zhuān)注于以問(wèn)題為導(dǎo)向的基礎(chǔ)性、前沿性的高端研究;立足深圳,對(duì)以金融科技(Fin-Tech)為代表的當(dāng)今中國(guó)金融改革與發(fā)展中的現(xiàn)實(shí)金融問(wèn)題為切入口,金融科技的研究側(cè)重于解決新技術(shù)在產(chǎn)業(yè)化過(guò)程中遇到的關(guān)鍵問(wèn)題。既服務(wù)于政府,為降低金融科技風(fēng)險(xiǎn)提供監(jiān)管建議。也同時(shí)服務(wù)于商業(yè)化應(yīng)用與科技孵化,對(duì)金融科技業(yè)務(wù)進(jìn)行梳理,對(duì)可能的風(fēng)險(xiǎn)進(jìn)行分析。促進(jìn)金融科技產(chǎn)學(xué)研協(xié)同發(fā)展。深耕深圳,以支持產(chǎn)業(yè)發(fā)展為中心,兼顧教學(xué)與研究,既服務(wù)深圳,也為全國(guó)金融科技案例庫(kù)的建設(shè)提供示范與樣板。打造國(guó)際一流的產(chǎn)學(xué)研一體化的金融智庫(kù)與金融科技商業(yè)孵化平臺(tái),為推動(dòng)我國(guó)的金融創(chuàng)新和維護(hù)創(chuàng)新中的金融穩(wěn)定提供專(zhuān)業(yè)支持。
南方科技大學(xué)智能管理與創(chuàng)新發(fā)展研究中心
本中心研究領(lǐng)域?yàn)椤爸悄芄芾砗蛣?chuàng)新發(fā)展”,包括但不限于智能管理及社會(huì)治理創(chuàng)新發(fā)展、智能制造與供應(yīng)鏈管理、大數(shù)據(jù)金融智能管理與創(chuàng)新、數(shù)據(jù)驅(qū)動(dòng)的智能決策和創(chuàng)新政策研究等等,關(guān)注的問(wèn)題聚焦于三個(gè)方向:基于信息技術(shù)的信用管理及政策研究,智能制造與供應(yīng)鏈管理,大數(shù)據(jù)驅(qū)動(dòng)的金融管理,這三個(gè)主攻方向既結(jié)合了深圳市目前的產(chǎn)業(yè)優(yōu)勢(shì),又面向著深圳未來(lái)經(jīng)濟(jì)發(fā)展規(guī)劃中的重要方向。本中心旨在響應(yīng)黨的十九大“增強(qiáng)城市管理精細(xì)化管理水平”的號(hào)召,發(fā)展新的管理方法和管理技術(shù),提升深圳市政府及企事業(yè)單位的科學(xué)管理能力,為深圳市實(shí)現(xiàn)追趕超越提供強(qiáng)大的“軟”實(shí)力。


南方科技大學(xué)文化遺產(chǎn)研究中心
南方科技大學(xué)文化遺產(chǎn)研究中心是深圳市人文社會(huì)科學(xué)重點(diǎn)研究基地。文化遺產(chǎn)研究中心主要依托社會(huì)科學(xué)中心以及其所屬的文化遺產(chǎn)實(shí)驗(yàn)室,設(shè)兩大研究方向:(1)以深圳為核心兼及粵港澳大灣區(qū)的考古學(xué)與史前史研究,(2)圍繞文化遺產(chǎn)進(jìn)行的延展應(yīng)用研究。通過(guò)系統(tǒng)收集、整理深圳及粵港澳大灣區(qū)的考古資料,開(kāi)展深圳史前史研究,同時(shí)開(kāi)展文化遺產(chǎn)應(yīng)用與城市發(fā)展的相關(guān)性研究,將南方科技大學(xué)文化遺產(chǎn)研究中心建設(shè)成為有數(shù)據(jù)、有設(shè)備、有團(tuán)隊(duì)、有成果、有一定規(guī)模的文化遺產(chǎn)科研平臺(tái),承擔(dān)深圳市以及粵港澳大灣區(qū)文化遺產(chǎn)研究、保護(hù)與利用的科研任務(wù),并為全國(guó)文化遺產(chǎn)事業(yè)發(fā)展提供思路與案例。
南方科技大學(xué)粵港澳大灣區(qū)科技人文與創(chuàng)新文化研究中心
“南方科技大學(xué)粵港澳大灣區(qū)科技人文與創(chuàng)新文化研究中心”是深圳市人文社會(huì)科學(xué)重點(diǎn)研究基地之一。作為整合南方科技大學(xué)人文科學(xué)中心各機(jī)構(gòu)而建立的跨學(xué)科研究機(jī)構(gòu),研究中心以“科技人文”和“創(chuàng)新文化”為核心,以語(yǔ)言學(xué)的社會(huì)應(yīng)用、科幻創(chuàng)作與科幻產(chǎn)業(yè)、建筑美學(xué)與空間設(shè)計(jì)、文明研究范式、哲學(xué)應(yīng)用與先行示范區(qū)建設(shè)、青年創(chuàng)新文化研究等模塊為抓手,打破學(xué)科壁壘,集中探索、揭示粵港澳大灣區(qū)科技創(chuàng)新與人文因子跨界融通所產(chǎn)生的文化新質(zhì),針對(duì)科技飛速發(fā)展時(shí)代人文研究的新問(wèn)題,探索新文科的方法論體系;同時(shí)從文化研究拓展到文明研究,打造面向生態(tài)文明的文化與文明研究理論體系。


南方科技大學(xué)全球城市文明典范研究院
南方科技大學(xué)全球城市文明典范研究院以城市文明典范建設(shè)為載體,為深圳全面建設(shè)中國(guó)特色社會(huì)主義先行示范區(qū)、全力打造“城市文明典范”提供高水平智力支持?;貒@“學(xué)術(shù)與智庫(kù)并重,理論與實(shí)踐相結(jié)合,全球城市文明典范研究院將為打造中國(guó)特色新型國(guó)際化智庫(kù)”發(fā)出“深圳最強(qiáng)音”,并致力于成為粵港澳大灣區(qū)和深圳學(xué)術(shù)創(chuàng)新探索的重要載體。
南方科技大學(xué)人工智能教育研究中心
南方科技大學(xué)人工智能教育研究中心依托深圳的科技創(chuàng)新優(yōu)勢(shì),聚焦人工智能驅(qū)動(dòng)的教育變革,致力于打造智能教育新生態(tài)。中心圍繞智能課堂、智慧學(xué)習(xí)環(huán)境、教育機(jī)器人等前沿領(lǐng)域,探索AI技術(shù)在教學(xué)中的創(chuàng)新應(yīng)用;深入研究人工智能賦能教育治理、智能測(cè)評(píng)與資源優(yōu)化,推動(dòng)因材施教、學(xué)習(xí)分析及個(gè)性化推薦系統(tǒng)的發(fā)展。中心積極構(gòu)建教育公平與個(gè)性化發(fā)展的智能支撐體系,助力深圳打造國(guó)際領(lǐng)先的智能教育示范區(qū),為教育現(xiàn)代化和社會(huì)可持續(xù)發(fā)展提供科學(xué)決策支持和技術(shù)引領(lǐng)。

